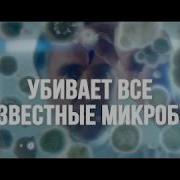

Трек: Domestos Убивает Все Известные Микробы
Загрузил: Domestos Russia
Длительность: 6 сек
Размер: 234.4 КБ
Битрейт: 320 Kbpsp
Прослушиваний: 27,811
Сейчас слушают
Косяк Горит Cover Version
Top Erger Mix 2026
Erkusov
Michael Bennetty Saranah Thompson Stunning Live Duet That Shook Everyone
Мужик Из Сибири Александр Конев Хотеть Не Вредно Official Video 2026 Meloman Hit
Кание Белые Розы Та
С С Кеч Кавер
Zoopals In G Major 464
Dj Power Get A Way 2026 90S Eurodance Remix
One Piece Bounty Rush Eggplant Sanji Voice Japanese
Milestone Iv John Doe Chase Theme Forsaken Ust
Windows Infinity Effects
Синие Розы В Стиле Юрия Шатунова Новый Хит 2026 Dark Flame Music
Знак Водолея Песня
Кеше Белан Кеше Аралаша Кеше Белан Кеше
Donde Arde Tu Recuerdo От Jerry S Sound Room
Jeff Zarling The Border
Namiq Sen O Kessen 2026
The Prism Of Saturn
Лучший Хит Шансона Месяца Новинка 2026
Rosa Damask
It S Just A Teddy Bear Meme
Все Идет По Плану
Песня Огонь Любви Новинка 2026
Eternal Drift V 2
Gummy Bear Rytp
Timeless The End Is Nigh
Uzbek Fristayler 2025 Music
Lucas And Steve Janieck
Cutting Crew Died In Your Arms Mad Morello Igi Remix
Я Живу И Слава Богу
Kanye West Silver Night Седая Ночь
Сборник Песен Эдуарда Хиля
Смотреть все